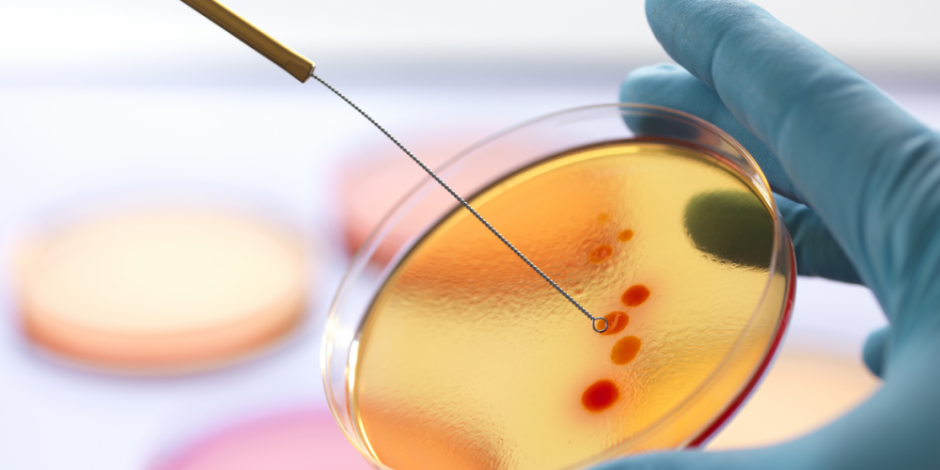

M&G Investments: Impact Investing am Beispiel Quest Diagnostics
Die Gesundheit im Fokus: Ein positiver gesellschaftlicher Beitrag durch Quest Diagnostics, den führenden Anbieter von diagnostischen Informationsdiensten.
28.06.2021 | 08:06 Uhr
Nur für professionelle Anleger.
2018 haben wir den M&G (Lux) Positive Impact Fund aufgelegt. John William Olsen, Fondsmanager des Fonds setzt auf Unternehmen, die einen effektiven Beitrag zur Lösung der großen Klima- und sozialen Probleme der Welt leisten. Allerdings müssen Aktien, die für den Fonds infrage kommen, auch die Aussicht auf attraktive Anlageergebnisse bieten. So investiert der Fonds in sechs verschiedene Impact-Bereiche – drei mit einem sozialen und drei mit einem ökologischen Schwerpunkt.
In unserer „M&G Impact Serie“ stellen wir Ihnen jeweils ein Unternehmen vor, in das wir investiert sind. Es ist wichtig zu betonen, dass unser Fonds kein reiner Klimawandel-Fonds ist, bei dem es allein um den CO -Fußabdruck gehen würde, sondern stattdessen eine breitere Sichtweise auf Impact Investing hat.
Impact Investing - Am Beispiel Quest Diagnostics
Führender Anbieter von diagnostischen Informationsdiensten
Quest Diagnostics ist ein in den USA börsennotiertes klinisches Labor, das diagnostische Dienstleistungen und Lösungen für bessere Gesundheit und Wohlbefinden anbietet. Das Unternehmen ist in zwei Geschäftsbereichen tätig: Diagnostic Information Services und Diagnostic Solutions. Der Geschäftsbereich Diagnostic Information Services entwickelt und liefert Informationen und Dienstleistungen für diagnostische Tests. Damit bietet er einer Reihe von Stakeholdern wichtige Einblicke – einschließlich Patienten, Ärzten, Krankenhäusern, integrierten Liefernetzwerken(IDNs), Anbietern von Gesundheitsplänen, Arbeitgebern und verantwortlichen Pflegeorganisationen(ACOs). Die Diagnostic Solutions-Gruppe umfasst den Geschäftsbereich Risikobewertung, die Lösungen für Versicherer anbietet, und den Geschäftsbereich Gesundheits-IT mit lösungen für Gesundheitsdiestleister, der sich an Gesundheitsdienstleister wendet.
Quest verfügt über die größte Datenbank klinischer Laborergebnisse in den USA, aus denen das Unternehmen seine Erkenntnisse im Diagnosebereich gewinnt. Auf dieser Basis erschließt es neue Wege zur Erkennung und Behandlung von Krankheiten, regt zu einem gesünderen Verhalten an und verbessert das Gesundheitsmanagement. Das Unternehmen besitzt Labore, Patientenservicezentren, Büros und andere Einrichtungen, vorwiegend an Standorten in den USA, aber auch in Puerto Rico, Mexiko, Brasilien und Indien.
Quest wurde ursprünglich im Jahr 1967 unter dem Namen Metropolitan Pathology Laboratory gegründet. Name und Eigentümerstruktur des Unternehmens änderten sich in den Folgejahren mehrfach. Durch die Ausgliederung aus dem multinationalen Technologiekonzern Corning wurde aus Quest Ende 1996 ein unabhängiges Unternehmen.
Seit der Jahrtausendwende war Quest an einer Reihe von wichtigen Akquisitionen und Partnerschaften beteiligt und erhielt dadurch Zugang zu einem größeren Spektrum von Patienten. Bedeutende Kooperationsverträge schloss das Unternehmen unter anderem 2016 mit Safeway und 2017 mit Walmart ab; seitdem kann es seine Laborleistungen in den Filialen dieser Supermarktketten anbieten. Im Mai 2018 gab Quest zudem bekannt, dass seine Labore künftig in das Netzwerk von UnitedHealthcare einbezogen werden, wodurch es Zugang zu 48 Millionen Krankenversicherten erhält. 2018 lancierte das Unternehmen auch QuestDirect, einen verbraucherorientierten Testdienst, der es Patienten erlaubt, Labortests bequem von zu Hause aus zu bestellen. Auf dieser Basis bot Quest selbstverständlich auch COVID-19- Testdienstleistungen an – zwischen März und Juli 2020 führte das Unternehmen mehr als 9,2 Millionen Molekulartests und 2,8 Millionen Serologietests auf COVID-19 durch.
Mit seinen Diagnoseleistungen ermöglicht Quest auch die Erkennung von nicht übertragbaren Krankheiten. Als führender Anbieter von Informationsdiensten im Diagnosebereich bedient das Unternehmen inzwischen rund 50% aller Krankenhäuser in den USA. In den nächsten drei Jahren will es seine Reichweite von rund einem Drittel auf die Hälfte der erwachsenen US-Bevölkerung ausweiten. Mit seiner Vision, „durch Erkenntnisse im Diagnosebereich für eine bessere Gesundheit zu sorgen“, unterstützt das Unternehmen besonders deutlich SDG 3: Gesundheit und Wohlergehen.
Auf einen Blick:
· Herkunftsland: USA
· Globale Ziele der Vereinten Nationen für nachhaltige Entwicklung (SDGs) – Ziel Nr. 3: Gesundheit und Wohlergehen
· Größter Anbieter von kostengünstigen diagnostischen Tests in den USA mit einer Marktkapitalisierung von 16,7 Milliarden US-Dollar
· Markenstärke, Größe und Reichweite sind in dem fragmentierten Markt schwer erreichbar
· Die Firmenvision lautet „Bessere Gesundheit durch diagnostische Erkenntnisse“ mit dem Ziel, „eine gesündere Welt zu fördern“
· Beliefert etwa 50 % der Krankenhäuser in den USA
· Versorgt 30 % der erwachsenen US-Bevölkerung und will den Anteil binnen drei Jahren auf 50 % steigern
- Der M&G (Lux) Positive Impact Fund investiert in Quest Diagnostics.
Wir unterstützen die SDGs der Vereinten Nationen, sind aber nicht mit den Vereinten Nationen assoziiert. Unsere Fonds werden nicht von der UN unterstützt.
Nelson Mandela sagte einmal Bildung sei die mächtigste Waffe um die Welt zu verändern. Leider haben nicht alle Menschen dieser Welt den gleich Zugang zu Bildung. Genau das möchte Cogna Educação in Brasilien ändern. Wie? Dies erfahren Sie nächste Woche in einem weiteren spannenden Artikel.
Alle Unternehmensdaten stammen von Quest Diagnostics. Die genannten Zahlen sind die zuletzt verfügbaren aus der Unternehmensliteratur, Stand: Januar 2021.
Der Wert der Vermögenswerte des Fonds und die daraus resultierenden Erträge können sowohl fallen als auch steigen. Dies führt dazu, dass der Wert Ihrer Anlage fallen und steigen wird. Es gibt keine Garantie dafür, dass der Fonds sein Ziel erreichen wird, und Sie bekommen möglicherweise weniger zurück, als Sie ursprünglich investiert haben.
Die in diesem Dokument zum Ausdruck gebrachten Ansichten sollten nicht als Empfehlung, Beratung oder Prognose aufgefasst werden.
Der Fonds investiert überwiegend in Gesellschaftsaktien, und es ist daher wahrscheinlich, dass er größeren Preisschwankungen unterliegt als Fonds, die in Obligationen oder Bargeld investieren.
Das vorliegende Dokument richtet sich ausschließlich an professionelle Anleger und ist nicht zur Weitergabe bestimmt. Andere Personen sollten sich nicht auf die hierin enthaltenen Informationen verlassen. Die Weiterleitung dieses Dokuments in oder von der Schweiz aus ist nicht zulässig, mit Ausnahme der Weitergabe an Qualifizierte Anleger („Qualifizierte Anleger“) im Sinne des Schweizerischen Kollektivanlagengesetzes, der Schweizerischen Kollektivanlagenverordnung und des entsprechenden Rundschreibens der Schweizerischen Aufsichtsbehörde. Ausschließlich für den Gebrauch durch den ursprünglichen Empfänger bestimmt (vorausgesetzt dieser ist ein Qualifizierter Anleger). Bei den, in diesem Dokument erwähnten kollektiven Kapitalanlagen (die „Fonds“), handelt es sich um offene Investmentgesellschaften mit variablem Kapital, die im Fall von M&G Investment Funds in England und Wales und im Fall von M&G (Lux) Investment Funds in Luxemburg eingetragen sind. Diese Informationen sind nicht als Angebot oder Aufforderung zum Kauf von Anteilen an einem der hier erwähnten Fonds zu verstehen. Zeichnungen von Anteilen eines Fonds sollten nur auf der Grundlage des aktuellen Verkaufsprospekts erfolgen. Die Gründungsurkunde, Verkaufsprospekte, die Wesentlichen Anlegerinformationen, der Jahres- oder Halbjahresbericht und Geschäftsberichte sind in gedruckter Form kostenlos von einem der folgenden Vertreibern – M&G International Investments S.A., Deutsche Niederlassung, mainBuilding, Taunusanlage 19, 60325 Frankfurt am Main oder der österreichischen Zahlstelle Société Générale Zweigniederlassung Wien, Prinz Eugen-Strasse, 8-10/5/Top 11 A-1040 Wien, Österreich oder der Luxemburger Zahlstelle Société Générale Bank & Trust SA, Centre operational 28-32, Place de la Gare L‑1616 Luxembourg. Für die Schweiz sind die Informationen von M&G International Investments Switzerland AG, Talstrasse 66, 8001 Zürich oder Société Générale, Paris, Zweigniederlassung Zürich, Talacker 50, P.O. Box 5070, 8021 Zürich, die als die Schweizer Vertreterin der Fonds (die „Schweizer Vertreterin“) und als deren Schweizer Zahlstelle fungiert, erhältlich. Für Deutschland und Österreich können Sie englische Kopien der Gründungsurkunde, des Jahres- oder Halbjahresberichts, des Geschäftsberichts und des Verkaufsprospekts ebenso erhalten wie deutschsprachige Kopien der Wesentlichen Anlegerinformationen.Bitte lesen Sie vor der Zeichnung von Anteilen den Verkaufsprospekt, in dem die mit diesen Fonds verbundenen Anlagerisiken aufgeführt sind. Diese Finanzwerbung wird herausgegeben von M&G International Investments S.A. Eingetragener Sitz: 16, boulevard Royal, L‑2449, Luxembourg.

Diesen Beitrag teilen: